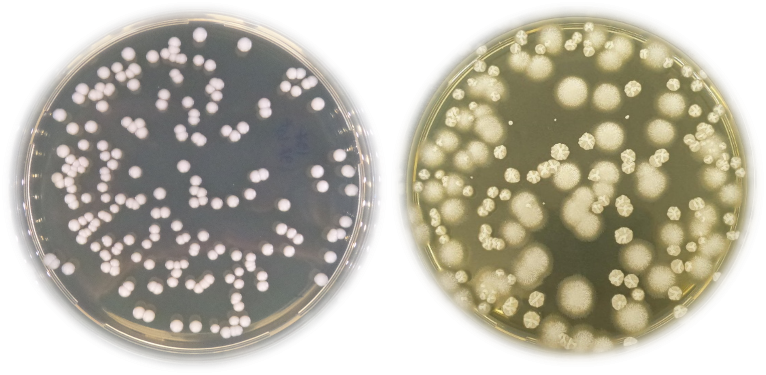

Aflați câteva informații despre borșul din România
Când spui ciorbă românească, te gândești automat la borș, acel lichid acru și aromat obținut prin fermentarea tărâțelor de grâu sau secară, care dă savoare mâncării. Numele de borș provine din cuvântul slav borscht, chiar dacă cele două au semnificații relativ diferite. Popoarele slave numesc borș ciorba de sfeclă roșie servită rece sau caldă, cu sau fără carne. Există zone și în România (Moldova, Delta Dunării), unde acest termen este folosit pentru a denumi toate ciorbele, indiferent că sunt acrite cu borș, oțet sau zeamă de varză. Totuși, în accepțiunea largă, termenul borș definește doar ingredientul folosit pentru a acri ciorba. Iar românii sunt singurii care folosesc acest produs pentru acrirea ciorbelor. În plus, borșul poate fi consumat și ca atare, datorită gustului plăcut, revigorant, dar și datorită efectelor benefice asupra sănătății.
Cum se prepară borșul?
Dacă întrebi 10 persoane cum prepară borșul acasă, probail vei afla 10 rețete diferite. Totuși, ingredientele de bază sunt identice, și anume: tărâțe de grâu sau secară, apă și huște (sunt tărâțe rămase de la fermentația anterioară și se folosesc ca inocul). Pentru aromă, se adaugă, în funcție de preferințe, frunze și crenguțe de vișin, leuștean, mălai etc.
În general, tărâțele sunt înmuiate în puțină apă, apoi se adaugă apă fierbinte, se lasă să se răcorească și se adaugă huște și ingredientele ”speciale”. Se lasă totul la fermentat, într-un loc călduț. De obicei, acest proces durează 24 de ore, după care lichidul se strecoară în sticle, care se păstrează la rece.
Din păcate, interesul pentru prepararea borșului în casă a scăzut mult în ultimul timp. Acesta se găsește acum în orice magazin alimentar sau poate fi cumpărat din piețele agroalimentare.
Care sunt beneficiile consumului de borș?
În primul rând, borșul conține un complex de microorganisme, în principal bacterii lactice și levuri, care contribuie la fermentarea tărâțelor, microorganisme cunoscute pentru efectul lor probiotic. De asemenea, prin fermentație sunt eliberați nutrienți esențiali, cum ar fi: vitamine, minerale și oligoelemente, aminoacizi esențiali, carbohidrați, enzime etc. Datorită acestor proprietăți, borșul are multiple beneficii pentru sănătate, chiar dacă acestea nu au fost probate prin studii clinice.
În tradiția populară, borșul este cunoscut ca unul dintre cele mai eficiente remedii pentru mahmureală, dar și pentru revigorarea organismului sau pentru combaterea anemiilor. Cura cu borș este considerată ca fiind benefică pentru afecțiunile digestive (indigestie, constipație, diaree) sau respiratorii (sinuzită, bronșite, astm), dar contribuie și la reglarea glicemiei, la menținerea sănătății aparatului cardiovascular și la protejarea organismului împotriva infecțiilor. Mai mult, oamenii consumă borș pentru eliminarea toxinelor din organism sau în curele de slăbire, datorită efectului tonic, corelat, însă, cu un număr mic de calorii.
Borșul în proiectul HealthFerm
În cadrul proiectului HealthFerm, ne-am propus să investigăm compoziția microbiană a borșului românesc și să vedem cum se corelează aceasta cu zonele geografice de proveniență, cu tipul de borș (făcut în casă sau provenit de la o fabrică) și cu compoziția chimică a acestuia.
În acest scop, am colectat 33 de probe de borș, care au fost analizate din punct de vedere microbiologic în Departamentul de Microbiologie al Institutului de Biologie București. Au fost atât probe primite de la persoane care fac borș acasă, cât și probe din produse comerciale (cumpărate din supermarket sau piețe agroalimentare).

Figure 1. Probe de borș colectate în proiectul HealthFerm
Cum analizăm compoziția microbiană?
Pentru aceasta folosim medii de cultură specifice, care sunt inoculate cu diluții din probele de borș primite, iar apoi incubate la o temperatură de 30°C, temperatură la care se dezvoltă microorganismele (Figura 2).
Figure 2. Aspectul coloniilor de bacterii lactice (stânga) și de levuri (dreapta) dezvoltate pe medii specifice
În acest fel au fost izolate peste 380 de bacterii și peste 70 de levuri. Ele sunt păstrate în criotuburi, la o temperatură foarte scăzută (-80°C), în mediul lor de creștere suplimentat cu glicerol, care le protejează față de îngheț.

Figure 3. Criotuburi cu microorganisme izolate din probele de borș
Cum identificăm microorganismele?
Din toate aceste izolate microbiene am extras materialul genetic (ADN), folosind kituri speciale, iar apoi am amplificat secvența unei gene din ADN-ul fiecărui microorganism. Pe baza secvenței acestei gene, care este specifică unei anumite specii microbiene (un fel de CNP al speciei), vor fi identificate bacteriile izolate din fiecare probă de borș.
Studiile sunt în curs de finalizare și vă vom ține la curent cu rezultatele obținute. Așa că, fiți cu ochii pe blogul nostru!

